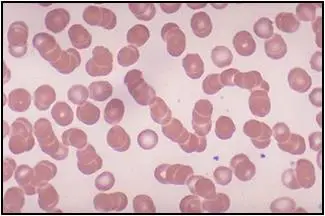
圖片描述

113年:(醫檢)血液(2)
一位70歲男性,提菜竟造成右手骨折,醫師懷疑是病理性骨折。抽血發現Hb只有9.3 g/dL,且有腎衰竭,血液抹片如圖示。下列何者是最有可能的診斷?
AThalassemia
BChronic lymphocytic leukemia
CMultiple myeloma
DMyeloproliferative neoplasm
詳細解析
本題觀念
本題核心在於辨識「CRAB」表徵(Calcium 增高、Renal failure、Anemia、Bone lesions)所提示的 multiple myeloma,並由周邊血塗片所見的紅血球堆疊(rouleaux formation)來輔助診斷。
影像分析
從周邊血塗片可見紅血球呈線狀串珠狀堆疊(rouleaux formation),即一枚枚紅血球像硬幣般沿長軸排列。這種現象反映血漿中單株免疫球蛋白濃度增高,使紅血球表面電荷屏障減弱,彼此黏附形成堆疊。rouleaux 在 multiple myeloma 患者中常見,可伴隨血沉率顯著升高 (webpathology.com)。
選項分析
-
選項A Thalassemia
Thalassemia 主要表現為微小細胞性貧血,周邊血常見 target cells、poikilocytosis,而非 rouleaux。此外,早期不會引起腎衰竭或病理性骨折,故不符本例臨床與形態學特徵。 -
選項B Chroni
...(解析預覽)...

升級 VIP 解鎖圖文解析